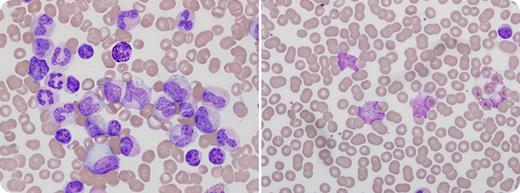
A 53-year-old man with a 9-year history of untreated chronic lymphocytic leukemia (CLL) was evaluated for marked leukocytosis. He had increased fatigue, low-volume axillary lymphadenopathy, and a palpable spleen. The leukocyte count was 294 × 109/L, hemoglobin 112 g/L, and platelet count 261 × 109/L. / His blood film (left) showed a spectrum of granulocytes with predominance of mature forms, and scattered small, mature lymphocytes. Bone marrow aspirate and biopsy showed marked granulocytic hyperplasia and small lymphoid aggregates with marked hypercellularity. Cytogenetic translocation (9;22)(q34;q11.2) and BCR-ABL1 positivity confirmed chronic myeloid leukemia (CML). The patient was treated with imatinib with a resolution of splenomegaly and a reversion of the bone marrow and blood film (right) to again show morphologic evidence of CLL. Posttreatment leukocyte count was 13 × 109/L with absolute lymphocytosis and scattered smudge cells, platelet count 161 × 109/L, and flow cytometry that affirmed CLL. / Patients with CLL have an increased frequency of various malignancies. However, the occurrence of CML with CLL is rare. In most reported instances, CML appears after an earlier diagnosis of CLL. These 2 leukemias appear to occur associated with separate genomic events.

A 53-year-old man with a 9-year history of untreated chronic lymphocytic leukemia (CLL) was evaluated for marked leukocytosis. He had increased fatigue, low-volume axillary lymphadenopathy, and a palpable spleen. The leukocyte count was 294 × 109/L, hemoglobin 112 g/L, and platelet count 261 × 109/L.
His blood film (left) showed a spectrum of granulocytes with predominance of mature forms, and scattered small, mature lymphocytes. Bone marrow aspirate and biopsy showed marked granulocytic hyperplasia and small lymphoid aggregates with marked hypercellularity. Cytogenetic translocation (9;22)(q34;q11.2) and BCR-ABL1 positivity confirmed chronic myeloid leukemia (CML). The patient was treated with imatinib with a resolution of splenomegaly and a reversion of the bone marrow and blood film (right) to again show morphologic evidence of CLL. Posttreatment leukocyte count was 13 × 109/L with absolute lymphocytosis and scattered smudge cells, platelet count 161 × 109/L, and flow cytometry that affirmed CLL.
Patients with CLL have an increased frequency of various malignancies. However, the occurrence of CML with CLL is rare. In most reported instances, CML appears after an earlier diagnosis of CLL. These 2 leukemias appear to occur associated with separate genomic events.
A 53-year-old man with a 9-year history of untreated chronic lymphocytic leukemia (CLL) was evaluated for marked leukocytosis. He had increased fatigue, low-volume axillary lymphadenopathy, and a palpable spleen. The leukocyte count was 294 × 109/L, hemoglobin 112 g/L, and platelet count 261 × 109/L.
His blood film (left) showed a spectrum of granulocytes with predominance of mature forms, and scattered small, mature lymphocytes. Bone marrow aspirate and biopsy showed marked granulocytic hyperplasia and small lymphoid aggregates with marked hypercellularity. Cytogenetic translocation (9;22)(q34;q11.2) and BCR-ABL1 positivity confirmed chronic myeloid leukemia (CML). The patient was treated with imatinib with a resolution of splenomegaly and a reversion of the bone marrow and blood film (right) to again show morphologic evidence of CLL. Posttreatment leukocyte count was 13 × 109/L with absolute lymphocytosis and scattered smudge cells, platelet count 161 × 109/L, and flow cytometry that affirmed CLL.
Patients with CLL have an increased frequency of various malignancies. However, the occurrence of CML with CLL is rare. In most reported instances, CML appears after an earlier diagnosis of CLL. These 2 leukemias appear to occur associated with separate genomic events.
Many Blood Work images are provided by the ASH IMAGE BANK, a reference and teaching tool that is continually updated with new atlas images and images of case studies. For more information or to contribute to the Image Bank, visit http://imagebank.hematology.org.
This feature is available to Subscribers Only
Sign In or Create an Account Close Modal